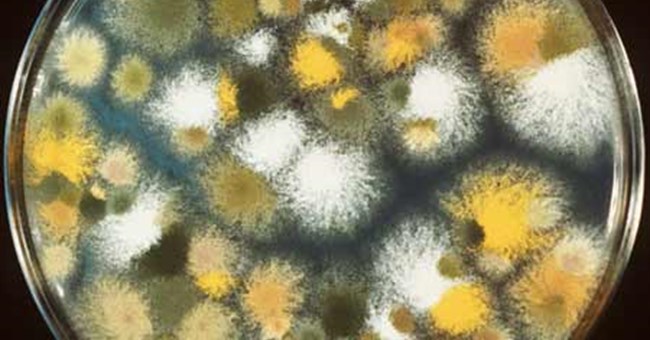
Mốc khúc (Aspergillus) - Tiến sĩ lên men

Sân trượt tuyết cực lớn trên nóc nhà máy năng lượng xanh ở Đan Mạch

Sáu năm trước, khi tập đoàn Bjarke Ingels công bố kế hoạch xây dựng nhà máy năng lượng xanh Copenhill có khả năng cung cấp cho thành phố Copenhagen điện.
Phát hiện thú vị mới về loài cừu

Cừu là một loài động vật thông minh hơn chúng ta từng nghĩ. Đó là kết quả một nghiên cứu khoa học được đăng trên tạp chí chuyên ngành "Royal Society Open Science" số ra mới đây.
Công nghệ mới ngăn thiết bị cũ thành rác độc hại

Theo nghiên cứu của Đại học Liên Hợp Quốc (Nhật Bản), mỗi năm thế giới thải ra 50 triệu tấn rác thải điện tử và chỉ 15% trong số này được xử lý.
Video: Công nghệ mới giúp hình xăm phát âm thanh

Đây là một hình xăm đặc biệt, một hình xăm sóng âm có thể phát ra âm thanh nhờ một ứng dụng mới trên smartphone có tên gọi là Skin Motion.
Sự thật kinh ngạc về bang Texas của Mỹ ít người biết

Theo trang List25.com, trong khoảng thời gian từ năm 1836 đến 1845, Texas từng là một quốc gia độc lập.
Những chiến lược bảo vệ Trái Đất khỏi thiên thạch của NASA

Hiện nay, chưa có loại vũ khí nào đủ mạnh để phá hủy một tiểu hành tinh khi phát hiện trong thời gian ngắn, theo RT.
Một động cơ tên lửa của SpaceX nổ trong khi thử nghiệm

Tuyên bố của SpaceX ngày 9/11 cho biết không ai bị thương và toàn bộ quy định về an toàn đã được thực hiện đầy đủ trong thời gian xảy ra sự cố.
Cấy não người mini vào chuột gây lo ngại về loài lai thông minh

Các nhà khoa học cấy mô não người vào đầu chuột cống và chuột nhắt, dấy lên một cuộc tranh cãi về đạo đức trong giới nghiên cứu.
Bí ẩn "xuyên không" kỳ lạ của viên ngọc 3500 năm tuổi

Các nhà khảo cổ học ở Đại học Cincinnati (UC), Ohio, Mỹ, phát hiện một viên ngọc mã não chạm khắc tinh xảo có thể thay đổi toàn bộ lịch sử nghệ thuật Hy Lạp cổ đại.
Áp thấp nhiệt đới mạnh lên thành bão Haikui

Tối qua áp thấp nhiệt đới đã mạnh lên thành bão với tên quốc tế Haikui, đây là cơn bão số 13 hoạt động trên biển Đông.
Trạm vũ trụ 8,5 tấn đi lạc sẽ tạo "mưa lửa" ở châu Âu?

Các chuyên gia dự đoán trạm vũ trụ Thiên Cung 1 nặng 8,5 tấn của Trung Quốc sẽ đâm xuống Trái đất vào đầu năm 2018.
Chúng ta có thể sống sót không, nếu chỉ ăn bánh mì và uống nước lọc?

Đôi khi chúng ta có những suy nghĩ khá lập dị, chẳng hạn như: “Liệu tôi có thể sống mà chỉ ăn món ăn yêu thích của mình suốt ngày?”.
Xác châu chấu mắc kẹt 128 năm trong tranh Van Gogh

Van Gogh nổi tiếng là người đề xướng phong cách vẽ tranh ngoài trời. Do đó, các chuyên gia cho rằng con châu chấu đã vô tình trở thành một phần của bức tranh khi ông đang làm việc bên ngoài.
 Lấy cảm hứng từ mẹ - người đã mất do căn bệnh này, Julian Rios Cantu một học sinh trung học từ Mexico đã thiết kế chiếc áo ngực giúp phát hiện sớm ung thư vú.
Lấy cảm hứng từ mẹ - người đã mất do căn bệnh này, Julian Rios Cantu một học sinh trung học từ Mexico đã thiết kế chiếc áo ngực giúp phát hiện sớm ung thư vú. Loài sâu Bobbit không chỉ có vẻ ngoài vô cùng đáng sợ mà chúng còn có khả năng săn mồi chớp nhoáng, khiến con mồi không kịp trở tay.
Loài sâu Bobbit không chỉ có vẻ ngoài vô cùng đáng sợ mà chúng còn có khả năng săn mồi chớp nhoáng, khiến con mồi không kịp trở tay. Nổi tiếng với ngành công nghiệp quốc phòng trứ danh, Israel mới đây đã cho ra mắt mẫu súng ngắn mới đáp ứng 4 tiêu chí tối thượng trong chiến đấu "hiệu quả, an toàn, dễ dùng, dễ sửa".
Nổi tiếng với ngành công nghiệp quốc phòng trứ danh, Israel mới đây đã cho ra mắt mẫu súng ngắn mới đáp ứng 4 tiêu chí tối thượng trong chiến đấu "hiệu quả, an toàn, dễ dùng, dễ sửa". Khoảng 65 triệu năm trước, một tiểu hành tinh va chạm với Trái Đất đã hủy diệt sự sống của loài khủng long.
Khoảng 65 triệu năm trước, một tiểu hành tinh va chạm với Trái Đất đã hủy diệt sự sống của loài khủng long. Sáng sớm 10/11, bão Haikui vào Biển Đông và trở thành cơn bão số 13 trên Biển Đông trong năm. Hướng di chuyển của cơn bão được dự báo phức tạp.
Sáng sớm 10/11, bão Haikui vào Biển Đông và trở thành cơn bão số 13 trên Biển Đông trong năm. Hướng di chuyển của cơn bão được dự báo phức tạp. Mỗi khi lang thang trong siêu thị, cửa hàng để mua đồ, bạn cho rằng mình sẽ hoàn toàn tỉnh táo khi cầm trên tay list đồ dùng cần mua và hô quyết tâm không mua thứ không cần để tiết kiệm tiền?
Mỗi khi lang thang trong siêu thị, cửa hàng để mua đồ, bạn cho rằng mình sẽ hoàn toàn tỉnh táo khi cầm trên tay list đồ dùng cần mua và hô quyết tâm không mua thứ không cần để tiết kiệm tiền? Ruồi giấm Drosophila subobscura thực hiện các nghi thức tán tỉnh đặc biệt nhờ một gene gọi là Fru.
Ruồi giấm Drosophila subobscura thực hiện các nghi thức tán tỉnh đặc biệt nhờ một gene gọi là Fru. Sáu năm trước, khi tập đoàn Bjarke Ingels công bố kế hoạch xây dựng nhà máy năng lượng xanh Copenhill có khả năng cung cấp cho thành phố Copenhagen điện.
Sáu năm trước, khi tập đoàn Bjarke Ingels công bố kế hoạch xây dựng nhà máy năng lượng xanh Copenhill có khả năng cung cấp cho thành phố Copenhagen điện. Cừu là một loài động vật thông minh hơn chúng ta từng nghĩ. Đó là kết quả một nghiên cứu khoa học được đăng trên tạp chí chuyên ngành "Royal Society Open Science" số ra mới đây.
Cừu là một loài động vật thông minh hơn chúng ta từng nghĩ. Đó là kết quả một nghiên cứu khoa học được đăng trên tạp chí chuyên ngành "Royal Society Open Science" số ra mới đây. Theo nghiên cứu của Đại học Liên Hợp Quốc (Nhật Bản), mỗi năm thế giới thải ra 50 triệu tấn rác thải điện tử và chỉ 15% trong số này được xử lý.
Theo nghiên cứu của Đại học Liên Hợp Quốc (Nhật Bản), mỗi năm thế giới thải ra 50 triệu tấn rác thải điện tử và chỉ 15% trong số này được xử lý. Đây là một hình xăm đặc biệt, một hình xăm sóng âm có thể phát ra âm thanh nhờ một ứng dụng mới trên smartphone có tên gọi là Skin Motion.
Đây là một hình xăm đặc biệt, một hình xăm sóng âm có thể phát ra âm thanh nhờ một ứng dụng mới trên smartphone có tên gọi là Skin Motion. Theo trang List25.com, trong khoảng thời gian từ năm 1836 đến 1845, Texas từng là một quốc gia độc lập.
Theo trang List25.com, trong khoảng thời gian từ năm 1836 đến 1845, Texas từng là một quốc gia độc lập. Hiện nay, chưa có loại vũ khí nào đủ mạnh để phá hủy một tiểu hành tinh khi phát hiện trong thời gian ngắn, theo RT.
Hiện nay, chưa có loại vũ khí nào đủ mạnh để phá hủy một tiểu hành tinh khi phát hiện trong thời gian ngắn, theo RT. Tuyên bố của SpaceX ngày 9/11 cho biết không ai bị thương và toàn bộ quy định về an toàn đã được thực hiện đầy đủ trong thời gian xảy ra sự cố.
Tuyên bố của SpaceX ngày 9/11 cho biết không ai bị thương và toàn bộ quy định về an toàn đã được thực hiện đầy đủ trong thời gian xảy ra sự cố. Các nhà khoa học cấy mô não người vào đầu chuột cống và chuột nhắt, dấy lên một cuộc tranh cãi về đạo đức trong giới nghiên cứu.
Các nhà khoa học cấy mô não người vào đầu chuột cống và chuột nhắt, dấy lên một cuộc tranh cãi về đạo đức trong giới nghiên cứu. Các nhà khảo cổ học ở Đại học Cincinnati (UC), Ohio, Mỹ, phát hiện một viên ngọc mã não chạm khắc tinh xảo có thể thay đổi toàn bộ lịch sử nghệ thuật Hy Lạp cổ đại.
Các nhà khảo cổ học ở Đại học Cincinnati (UC), Ohio, Mỹ, phát hiện một viên ngọc mã não chạm khắc tinh xảo có thể thay đổi toàn bộ lịch sử nghệ thuật Hy Lạp cổ đại. Tối qua áp thấp nhiệt đới đã mạnh lên thành bão với tên quốc tế Haikui, đây là cơn bão số 13 hoạt động trên biển Đông.
Tối qua áp thấp nhiệt đới đã mạnh lên thành bão với tên quốc tế Haikui, đây là cơn bão số 13 hoạt động trên biển Đông. Các chuyên gia dự đoán trạm vũ trụ Thiên Cung 1 nặng 8,5 tấn của Trung Quốc sẽ đâm xuống Trái đất vào đầu năm 2018.
Các chuyên gia dự đoán trạm vũ trụ Thiên Cung 1 nặng 8,5 tấn của Trung Quốc sẽ đâm xuống Trái đất vào đầu năm 2018. Đôi khi chúng ta có những suy nghĩ khá lập dị, chẳng hạn như: “Liệu tôi có thể sống mà chỉ ăn món ăn yêu thích của mình suốt ngày?”.
Đôi khi chúng ta có những suy nghĩ khá lập dị, chẳng hạn như: “Liệu tôi có thể sống mà chỉ ăn món ăn yêu thích của mình suốt ngày?”. Van Gogh nổi tiếng là người đề xướng phong cách vẽ tranh ngoài trời. Do đó, các chuyên gia cho rằng con châu chấu đã vô tình trở thành một phần của bức tranh khi ông đang làm việc bên ngoài.
Van Gogh nổi tiếng là người đề xướng phong cách vẽ tranh ngoài trời. Do đó, các chuyên gia cho rằng con châu chấu đã vô tình trở thành một phần của bức tranh khi ông đang làm việc bên ngoài.